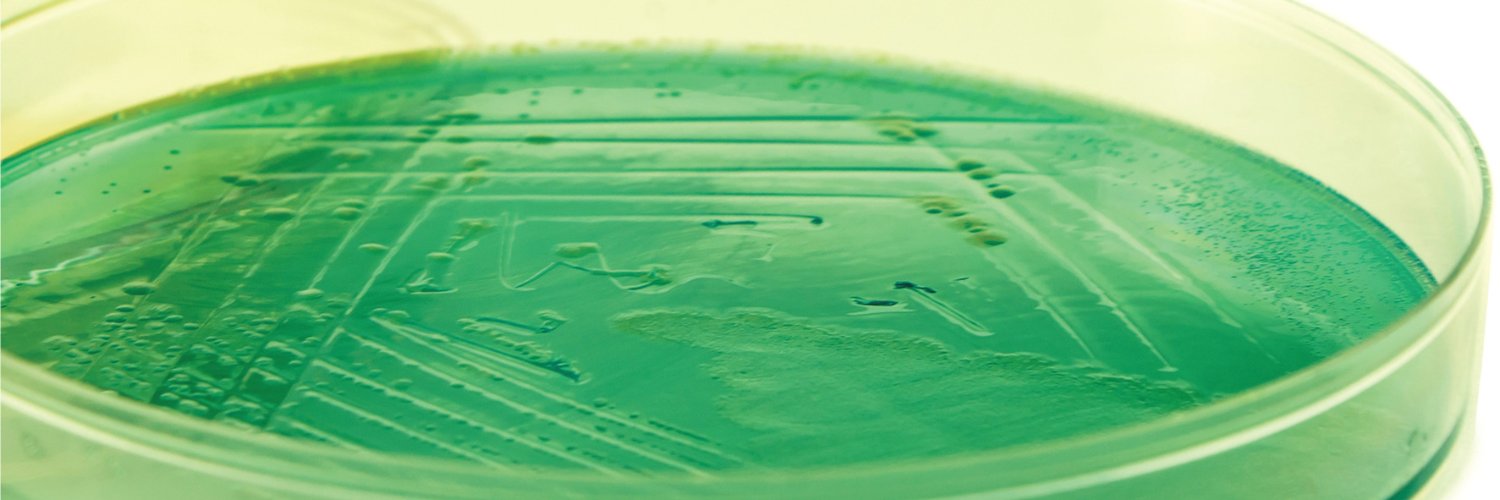
Pseudomonas Database banner

There were some recent performance issues with pseudomonas.com but they have now been resolved. We apologize for any impact this may have caused. Please don’t hesitate to contact us though if you still notice any problems.
English
Pseudomonas Database
699 posts

@pseudocap
Pseudomonas Genome Database updates and more...





















